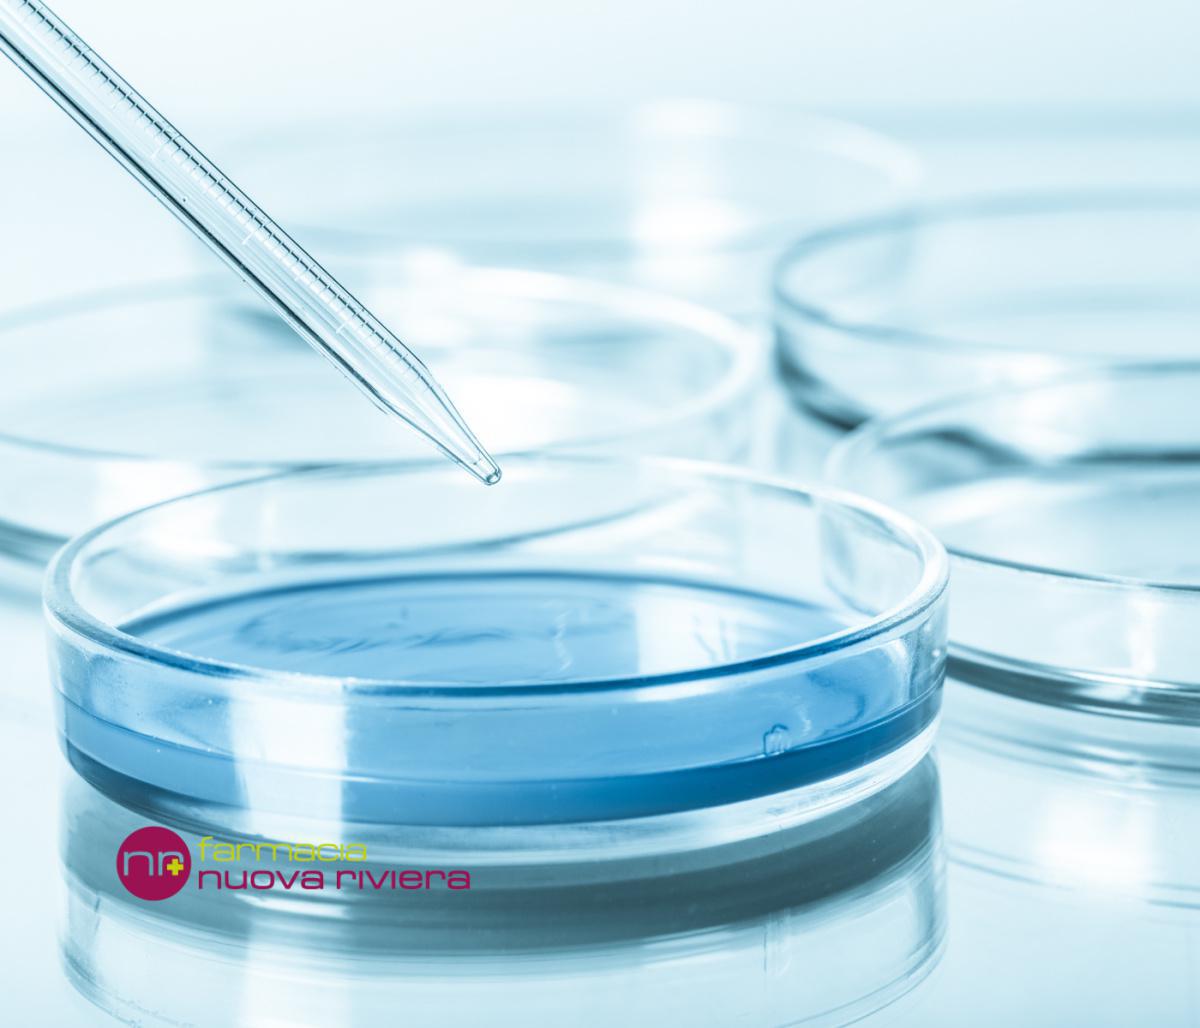
Analisi dell'acqua Analisi dell'acqua

Tramite un piccolo campione d'acqua, raccolta dal cliente presso la propria abitazione, è possibile misurare con precisione la sua purezza prendendo in considerazione diversi valori, tra cui PH, durezza, carica microbica totale e caratteri organolettici.
Per informazioni e costi chiamare in farmacia al numero 0414174690, oppure